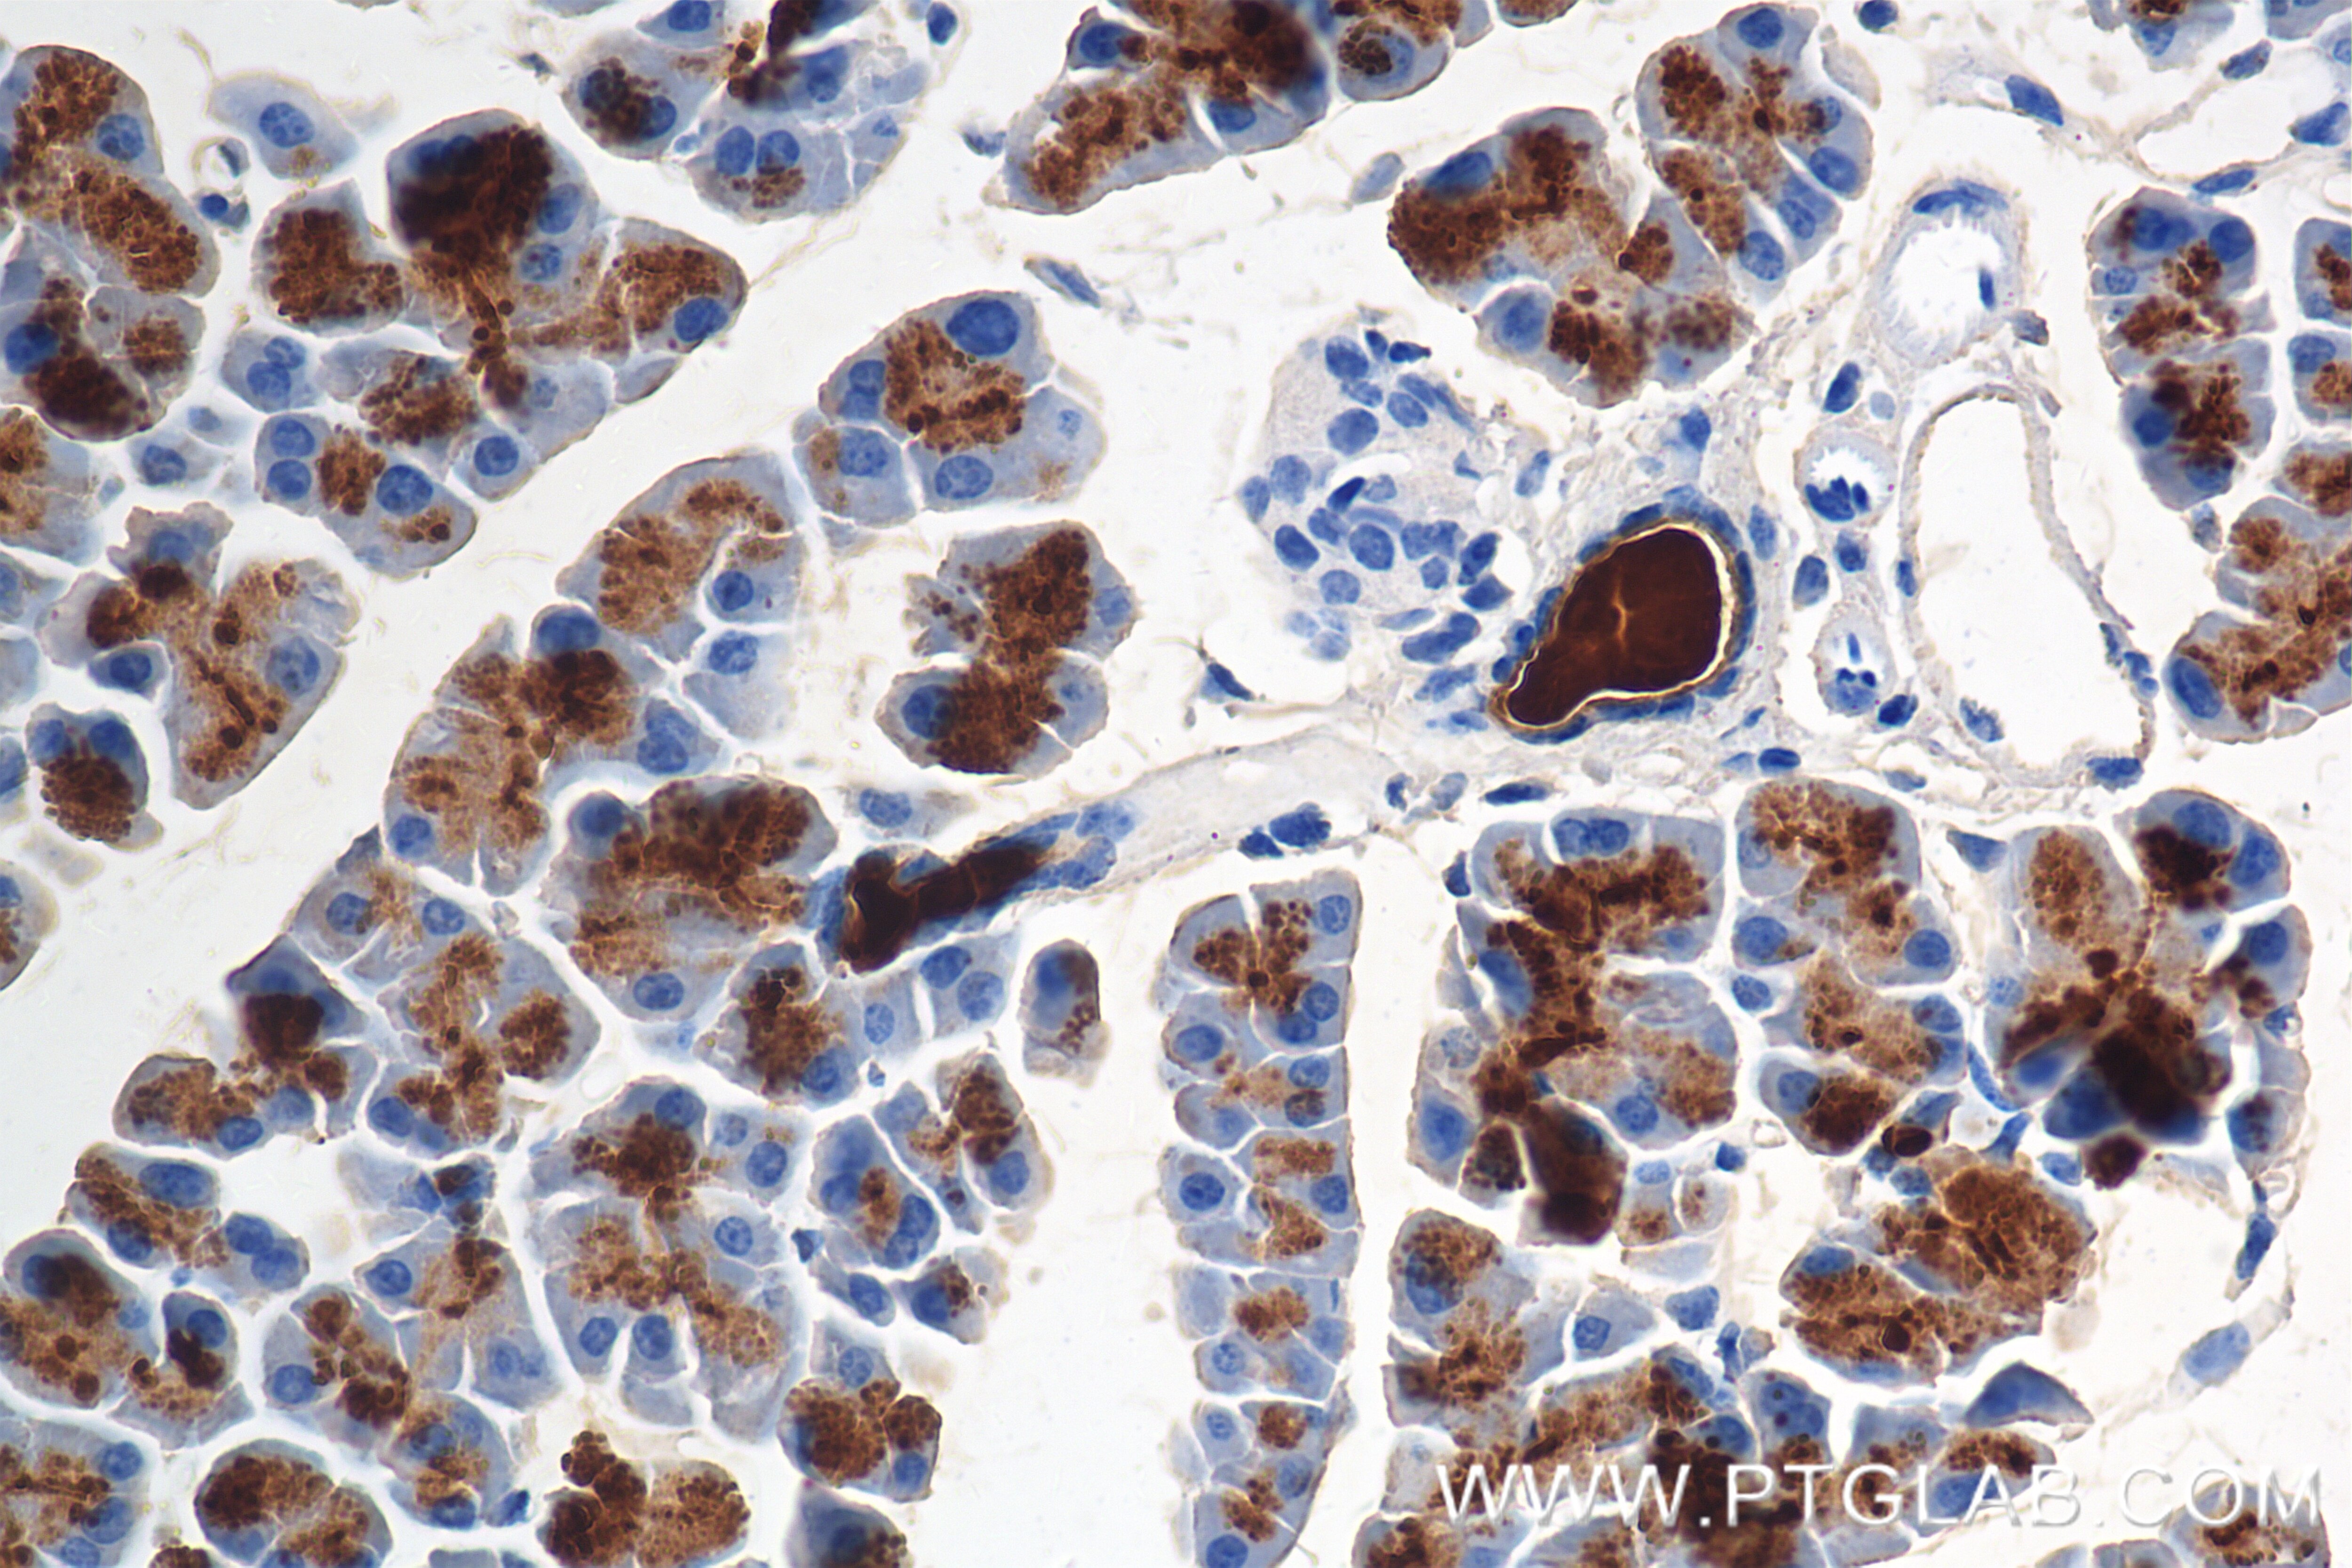
Immunohistochemical analysis of paraffin-embedded mouse pancreas tissue slide using 86143-1-RR (Klk1 antibody) at dilution of 1:1000 (under 40x lens). Heat mediated antigen retrieval with Tris-EDTA buffer (pH 9.0). Immunohistochemistry (IHC) staining of mouse pancreas tissue using Klk1 Recombinant antibody (86143-1-RR)

Tested Applications
| Positive WB detected in | mouse pancreas tissue |
| Positive IHC detected in | mouse pancreas tissue Note: suggested antigen retrieval with TE buffer pH 9.0; (*) Alternatively, antigen retrieval may be performed with citrate buffer pH 6.0 |
| Positive IF-P detected in | mouse pancreas tissue |
Recommended dilution
| Application | Dilution |
|---|---|
| Western Blot (WB) | WB : 1:2000-1:10000 |
| Immunohistochemistry (IHC) | IHC : 1:500-1:2000 |
| Immunofluorescence (IF)-P | IF-P : 1:50-1:500 |
| It is recommended that this reagent should be titrated in each testing system to obtain optimal results. | |
| Sample-dependent, Check data in validation data gallery. | |
Product Information
86143-1-RR targets Klk1 in WB, IHC, IF-P, ELISA applications and shows reactivity with mouse samples.
| Tested Reactivity | mouse |
| Host / Isotype | Rabbit / IgG |
| Class | Recombinant |
| Type | Antibody |
| Immunogen |
CatNo: Eg2996 Product name: recombinant mouse Klk1 protein Source: mammalian cells-derived, V37 Tag: C-rFc Domain: 19-261 aa of NM_001320331.1 Sequence: PPVQSRIVGGFNCEKNSQPWQVAVYRFTKYQCGGILLNANWVLTAAHCHNDKYQVWLGKNNFLEDEPSAQHRLVSKAIPHPDFNMSLLNEHTPQPEDDYSNDLMLLRLKKPADITDVVKPIDLPTEEPKLGSTCLASGWGSITPVKYEYPDELQCVNLKLLPNEDCAKAHIEKVTDDMLCAGDMDGGKDTCAGDSGGPLICDGVLQGITSWGPSPCGKPNVPGIYTRVLNFNTWIRETMAEND Predict reactive species |
| Full Name | kallikrein 1 |
| Calculated Molecular Weight | 29 kDa |
| Observed Molecular Weight | 28-34 kDa |
| GenBank Accession Number | NM_001320331.1 |
| Gene Symbol | Klk1 |
| Gene ID (NCBI) | 16612 |
| Conjugate | Unconjugated |
| Form | Liquid |
| Purification Method | Protein A purification |
| UNIPROT ID | P15947 |
| Storage Buffer | PBS with 0.02% sodium azide and 50% glycerol, pH 7.3. |
| Storage Conditions | Store at -20°C. Stable for one year after shipment. Aliquoting is unnecessary for -20oC storage. 20ul sizes contain 0.1% BSA. |
Background Information
Mouse KLK1 (Kallikrein-Related Peptidase 1) is a serine protease belonging to the kallikrein family with important physiological functions. KLK1 can cleave the Met-Lys and Arg-Ser bonds in kininogen to release Lys-bradykinin. Bradykinin plays an important role in regulating vasodilation, lowering blood pressure, smooth muscle relaxation and contraction, pain induction and inflammatory response.
Protocols
| Product Specific Protocols | |
|---|---|
| IF protocol for Klk1 antibody 86143-1-RR | Download protocol |
| IHC protocol for Klk1 antibody 86143-1-RR | Download protocol |
| WB protocol for Klk1 antibody 86143-1-RR | Download protocol |
| Standard Protocols | |
|---|---|
| Click here to view our Standard Protocols |